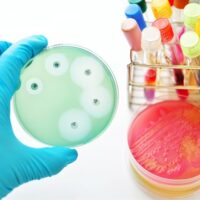

Category: Diseases & Treatments
Researchers at The Ottawa Hospital and the University of Ottawa have discovered an 18-digit code that allows proteins to attach themselves to exosomes – tiny pinched-off pieces of cells …
Inequalities in childhood vaccination are widening in England, with uptake rates of five key vaccines consistently lower in young children living in areas of higher deprivation from 2019 to …
Cigarette smoking from childhood into early adulthood is associated with an increased risk of premature cardiac injury, according to a study published today in JACC, the flagship journal of …
A complete blood count (CBC) screening is a routine exam requested by most physicians for healthy adults. This clinical test is a valuable tool for assessing a patient’s overall …
In the future, delivering therapeutic drugs exactly where they are needed within the body could be the task of miniature robots. Not little metal humanoid or even bio-mimicking robots; …
The arrival of Paxlovid in December 2021 marked another turning point in the COVID-19 pandemic-;an effective antiviral that has since successfully treated millions. But like many antivirals before it, …
Wiley, one of the world’s largest publishers and a global leader in research and learning, today announced the release of the new version of its KnowItAll software, with numerous …
Large-scale protein and gene profiling have massively expanded the landscape of cancer-associated proteins and gene mutations, but it has been difficult to discern whether they play an active role …
Patients with high-risk, BRCA-positive breast cancer who received olaparib (Lynparza) after standard treatment continued to have better survival outcomes than those who received placebo after a median follow-up of …
Many vitamins are produced in chemical factories, often synthetically, but researchers at the Technical University of Denmark have succeeded in developing a natural and simple method for producing vitamin …